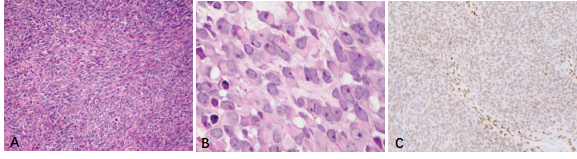

【新品推薦】SS18-SSX在臨床病理診斷中的應用
北京中杉金橋生物技術有限公司市場部 2022-04-02

SS18基因定位于18號染色體q11.2區域,編碼一種轉錄共激活因子。SSl8蛋白是染色體重塑復合物SWI/SNF的重要亞單位。SWI/SNF作用很廣泛,與細胞周期調控、干細胞特性維持及細胞分化相關,并發揮抑癌基因的作用。SSX基因定位于X染色體,家族由9個成員(SSX1-9)組成,編碼腫瘤/睪丸抗原,表達于睪丸和甲狀腺組織[1]。SS18-SSX為滑膜肉瘤(SS)的驅動因素及特異性融合基因,在其它腫瘤中未發現。與SS18蛋白類似,SSl8-SSX融合蛋白也可以構成SWI/SNF復合物,同時破壞復合物中抑癌基因BAF47(SMARCB1,INI-l)的作用,可以與Sox2基因位點結合,解除PRC2介導的轉錄抑制作用,激活Sox2表達,促進SS細胞增殖[2]。因此,SS18-SSX在臨床病理實踐中的應用主要體現在滑膜肉瘤的診斷及鑒別診斷:
1.?SS18-SSX是診斷滑膜肉瘤的特異性抗體。
滑膜肉瘤是一種大多數發生于四肢深部軟組織的具有間葉和上皮雙相分化的惡性腫瘤,占全部軟組織肉瘤的5%-10%,是第二常見的兒童肉瘤。滑膜肉瘤在各年齡段均可發病,好發于15-35歲的青少年及成人,以男性略多見。95%以上的滑膜肉瘤具有特征性的t(X;18)(p11.2;q11.2)染色體易位,導致SS18基因(以前稱為SYT)與SSX基因融合,產生SS18-SSX融合基因(其中2/3為SS18-SSX1,1/3為SS18-SSX2,SS18-SSX4罕見)。滑膜肉瘤與多種其他類型腫瘤存在形態學上的重疊,使其診斷具有極大的挑戰。免疫組織化學染色雖然常規用于滑膜肉瘤的輔助診斷,但目前仍缺乏特異性標志物。因此,最終的精準診斷仍依賴于細胞遺傳學及分子生物學檢測方法。
新近研發的針對SS融合蛋白連接處的特異性抗體SS18-SSX(克隆號E9X9V,圖1,引自參考文獻3)在滑膜肉瘤腫瘤細胞核呈中等至強陽性表達(圖2),其靈敏度和特異度分別達95%和100%[3, 4]。研究表明[5],SS18-SSX IHC在診斷SS方面和FISH等分子檢測方法具有很好的一致性(圖3,引自參考文獻5),甚至比其他方法檢測SS更有特異性,特別是在非典型FISH模式的病例中(圖4,引自參考文獻5),它與RNA測序結果有很好的相關性,有充分的證據說明此抗體在診斷SS方面已經替代了FISH檢測方法。
2. SS18-SSX在部分SMARCB1基因變異腫瘤中的鑒別診斷作用。
由于SSl8-SSX融合蛋白可以降低或破壞SWI/SNF復合物中BAF47的作用[2],而SMARCB1作為抑癌基因,98%的橫紋肌腫瘤、90%以上的上皮樣肉瘤以及50%以上的肌上皮癌發生此基因的缺失,因此當腫瘤免疫組化染色呈“無或微弱”的INI-1表達時[6](圖5,引自參考文獻6),我們需要考慮加染SSl8-SSX抗體來明確腫瘤是否本質為滑膜肉瘤的診斷。

圖1. 融合特異性抗體SS18-SSX(克隆號E9X9V)靶向的SS18-SSX融合基因序列示意圖(引自參考文獻3)

圖2.雙相型滑膜肉瘤(A.HE染色,中倍放大)。免疫組化染色SS18-SSX(E9X9V)腫瘤細胞核彌漫強陽性(B.低倍放大,C.高倍放大)

圖3.免疫組化染色SS18-SSX(E9X9V)強陽性,NGS測序證實具有滑膜肉瘤特征型的SS18-SSX融合基因(引自參考文獻5)

圖3.免疫組化染色SS18-SSX(E9X9V)強陽性,NGS測序證實具有滑膜肉瘤特征型的SS18-SSX融合基因(引自參考文獻5)
圖3.免疫組化染色SS18-SSX(E9X9V)強陽性,NGS測序證實具有滑膜肉瘤特征型的SS18-SSX融合基因(引自參考文獻5)
參考文獻
[1]?Ali O, Isaac J, Lioyd J. The SSX gene family: characterization of 9 complete genes. Int J Cancer, 2002, 101(5):448-453.
[2]?Matthew J, John L. The SS18-SSX Fusion Oncoprotein Hijacks BAF Complex Targeting and Function to Drive Synovial Sarcoma. Cancer Cell, 2018, 33(6):1128–1141.
[3]?E Baranov, M McBride, A Bellizzi. A Novel SS18-SSX Fusion-specific Antibody for the Diagnosis of Synovial Sarcoma. Am J Surg Pathol, 2020, 44(7):922-933.
[4]?Raul P, Valérie V, Sophie LG. The SS18-SSX Antibody Has Perfect Specificity for the SS18-SSX Fusion Protein: A Validation Study of 609 Neoplasms Including 2 Unclassified Tumors With SS18-Non-SSX Fusions. Am J Surg Pathol, 2021, 45(4):582-584.
[5]?TKY Tay, NB Sukma, TH Lim, et al. Correlating SS18-SSX immunohistochemistry (IHC) with SS18 fluorescent in situ hybridization (FISH) in synovial sarcomas: a study of 36 cases. Virchows Arch, 2021, 479(4):785-793.
[6]Kenichi K, Yoshinao O, Hidetaka Y. Reduced expression of SMARCB1/INI1 protein in synovial sarcoma. Modern Pathology, 2010, 23:981-990.
SS18-SSX
貨號:ZA-0699
克隆號:E9X9V

如需了解更多產品信息,請與我司聯系











